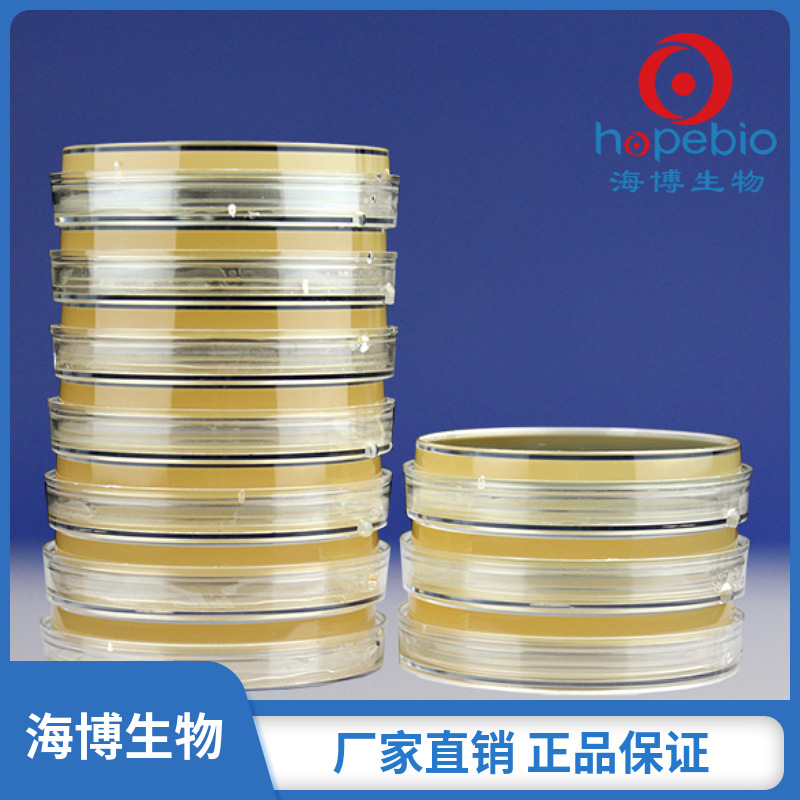
平板计数琼脂培养基9cm  	HBPM002   9cm*10个 青岛海博生物

1688工业品为您提供在线免费查询更多化学试剂详细参数、实时报价、规格一览表。更多关于化学试剂多少钱一瓶/化学试剂报价明细/化学试剂规格型号价格表/化学试剂批发市场价格/化学试剂官方报价等咨询,尽在1688工业品。询底价>
为你找到生化试剂相关产品

A36743-5mgCHIR-99021252917-06-998%科研使用
北京
在线询价

小鼠抗人IgG2 人IgG2单克隆抗体
北京
在线询价

福建含量达99%生化试剂培养基发酵动物性牛骨工业级蛋白胨OEM定制
福建厦门
在线询价
![Tris Dodecyl Sulfate [for Biochemical Research],50996-85-5](https://cbu01.alicdn.com/img/ibank/O1CN01h8K8Lb1TJNrGMilGG_!!2213611272361-0-cib.jpg)
Tris Dodecyl Sulfate [for Biochemical Research],50996-85-5
河北保定
在线询价
平板计数琼脂培养基9cm HBPM002 9cm*10个 青岛海博生物
山东青岛
在线询价

新品批发 环凯 022060 伊红美蓝琼脂培养基(EMB)培养基
广东广州
在线询价

BD紫红色胆汁葡萄糖琼脂 BD218661 BD VRBGA培养基 BD青药培养基
山东青岛
在线询价

儿茶酚紫 5g美国原产( Biofer分装)cas:115-41-3
上海
在线询价

0.85%生理盐水 用于样品稀释处理 9ml/10ml/支 无菌灌装 欧克生物
安徽芜湖
在线询价

硫酸软骨素B(来源于猪)≥99% 科研实验试剂CAS:9007-28-7
安徽合肥
在线询价

缓冲蛋白胨水(BPW)(均质袋)培养基【一次性成品培养基系列
江苏南京
在线询价

苹果酸脱氢酶(猪心),cas:9001-64-3
上海
在线询价
查看更多产品及报价
100+生化试剂相关产品等你解锁
AI找工业3000行家正在找货
AI找品,免费询价,源头正品,上1688工业品,全国的工业正品交易平台





